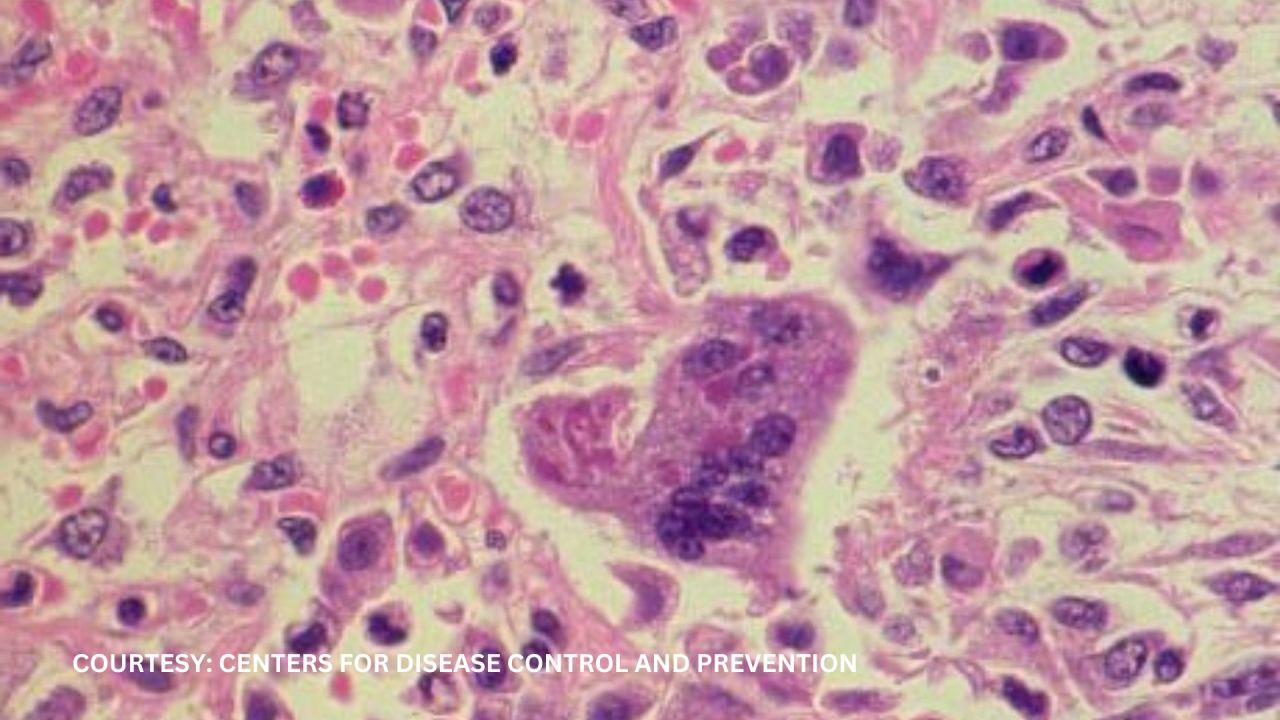

Zika Virus Returns to Popular U.S. Tourist Spot After Six Years
The Hawaii Department of Health has confirmed a case of Zika virus on Oahu, the first since 2019, prompting warnings for residents and visitors to use insect repellent and eliminate standing water to prevent mosquito bites, especially due to the virus's danger to pregnant women and its potential to cause severe fetal conditions.